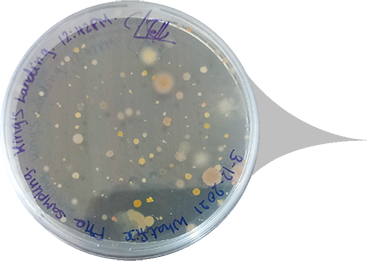
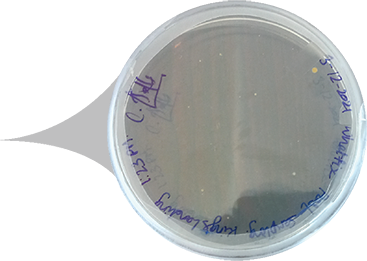

Our user-centric ZeBox technology has been validated for >99.999%
airborne-microbial reduction within 20 minutes, by an
ICMR/NABL/ISO-accredited laboratory.
Here’s how the ZeBox technology works


Air with microbes flows freely between the active surfaces

Microbes are pulled towards the active surfaces using an electric field

Chemistry on surface lyses microbes
Here’s how the ZeBox technology is tested

Chamber without device. Microbe count in millions

Device is introduced. Within a minute, microbe count starts reducing

Microbe count reduced by >99.999% within 20 minutes









